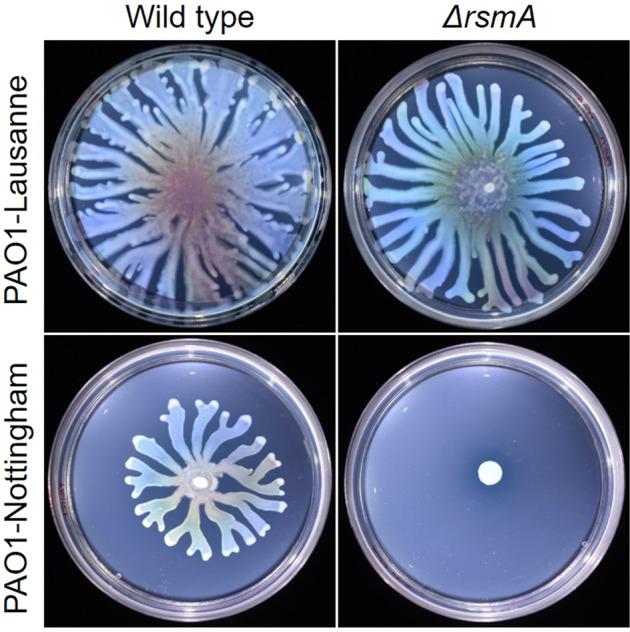
https://cdn.ncbi.nlm.nih.gov/pmc/blobs/ea06/9388670/86c6035c9bb4/41522_2022_325_Fig1_HTML.jpg

ToxR 是一种 c-di-GMP 结合蛋白,可调节铜绿假单胞菌的表面相关行为。
ToxR is a c-di-GMP binding protein that modulates surface-associated behaviour in Pseudomonas aeruginosa.
机构信息
National Biofilms Innovation Centre, Biodiscovery Institute and School of Life Sciences, University of Nottingham, Nottingham, UK.
School of Chemical and Biomolecular Engineering, University of Sydney, Sydney, Australia.
出版信息
NPJ Biofilms Microbiomes. 2022 Aug 18;8(1):64. doi: 10.1038/s41522-022-00325-9.
Pseudomonas aeruginosa uses multiple protein regulators that work in tandem to control the production of a wide range of virulence factors and facilitate rapid adaptation to diverse environmental conditions. In this opportunistic pathogen, ToxR was known to positively regulate the production of the major virulence factor exotoxin A and now, through analysis of genetic changes between two sublines of P. aeruginosa PAO1 and functional complementation of swarming, we have identified a previously unknown role of ToxR in surface-associated motility in P. aeruginosa. Further analysis revealed that ToxR had an impact on swarming motility by regulating the Rhl quorum sensing system and subsequent production of rhamnolipid surfactants. Additionally, ToxR was found to tightly bind cyclic diguanylate (c-di-GMP) and negatively affect traits controlled by this second messenger including reducing biofilm formation and the expression of Psl and Pel exopolysaccharides, necessary for attachment and sessile communities matrix scaffolding, in P. aeruginosa. Moreover, a link between the post-transcriptional regulator RsmA and toxR expression via the alternative sigma factor PvdS, induced under iron-limiting conditions, is established. This study reveals the importance of ToxR in a sophisticated regulation of free-living and biofilm-associated lifestyles, appropriate for establishing acute or chronic P. aeruginosa infections.
铜绿假单胞菌利用多种协同作用的蛋白质调节剂来控制多种毒力因子的产生,并促进其快速适应多样化的环境条件。在这种机会性病原体中,ToxR 被认为正向调节主要毒力因子外毒素 A 的产生,现在,通过分析铜绿假单胞菌 PAO1 的两个亚系之间的遗传变化和群集运动的功能互补,我们在铜绿假单胞菌中发现了 ToxR 在表面相关运动中的一个先前未知的作用。进一步的分析表明,ToxR 通过调节 Rh1 群体感应系统和随后产生鼠李糖脂表面活性剂来影响群集运动。此外,发现 ToxR 紧密结合环二鸟苷酸(c-di-GMP),并通过降低生物膜形成和 Psl 和 Pel 多糖的表达来影响该第二信使控制的特征,这对于附着和定殖社区基质支架是必需的。此外,还建立了在缺铁条件下诱导的转录后调节剂 RsmA 和 toxR 表达之间通过替代 sigma 因子 PvdS 的联系。这项研究揭示了 ToxR 在自由生活和生物膜相关生活方式的复杂调节中的重要性,这对于建立急性或慢性铜绿假单胞菌感染是合适的。